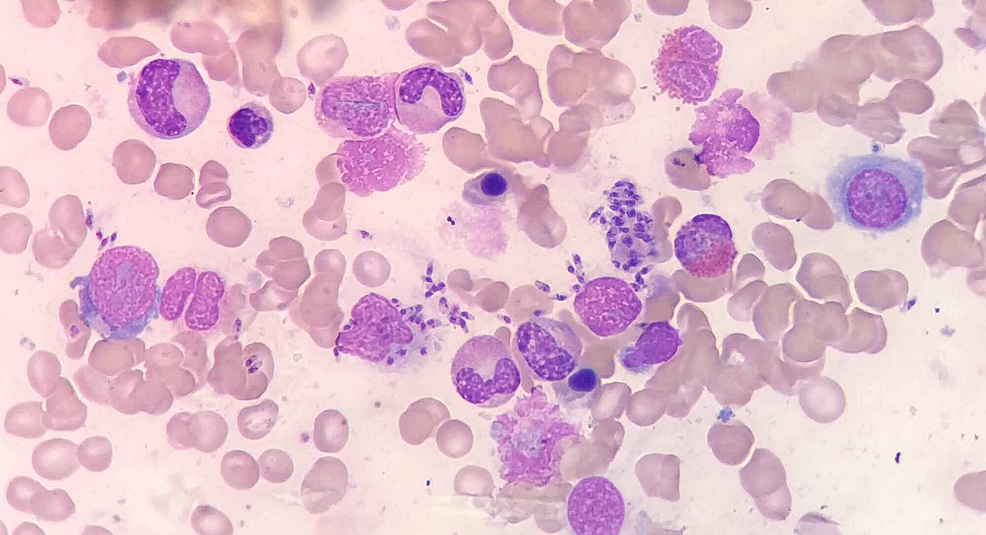

Leishmania donovani (Kala-Azar) – Basic microbiology, parasitology, and immunology; nature, reproduction, growth, and transmission of common microorganisms and parasites in Bangladesh; prevention including universal precaution and immunization, control, sterilization, and disinfection; and specimen collections and examination. Students will have an understanding of common organisms and parasites caused human diseases and acquire knowledge about the prevention and control of those organisms.
Leishmania donovani (Kala-Azar)
Classification of Leishmaniasis:

Types of Leishmania:
The genus Leishmania includes four major pathogens:
- Leishmania donovani
- Leishmania tropica
- Leishmania maxicana
- Leishmania braziliensis
Diseases Produced by Different Species of Leishmania
- Leishmania donovani – Kala-azar (visceral leishmaniasis), PKDL
- Leishmania tropica – Oriental sore (local lesion of skin and subcutaneous tissue)
- Leishmania brasiliensis – Espundia (local lesion of skin and oro-nasal mucosa)
The life cycle of L. donovani
- Amastigote form: in human.
- Promastigote form: in sand fly (infective form)
- Cycle:
Sandfly bite human
↓
Promastigote form liberated into the blood
↓
In human it is further converted into amastigote form.
↓
Amastigote forms multiply within macrophages of RE system by binary fission,
↓
Host cells enlarged and ruptured.
↓
They invade fresh cell and cycle repeated. Some are phagocytosed by neutrophil and monocyte.
↓
Sandfly takes amastigote form during sucking of blood.
↓
Amastigote form converted into promastigote form.
↓
Continuous multiplication within midgut by binary fission.
↓
Flagellates spread forwards to pharynx and buccal cavity. (Anterior station development.)
↓
Sandfly bite human
↓
Cycle is repeated.
kala-azar
Visceral leishmaniasis is called kala-azar which is caused by protozoa-Leishmania donovani, characterized by insidious onset of malaise, irregular fever, weight loss, anorexia, non-tender progressive splenomegaly without hepatomegaly, lymphadenopathy, darkening of the skin of the face, hands, feet and abdomen.
Epidemiology:
A. Occurrence: Worldwide distribution
B. Agent factors:
- Agent: Leishmania donovani
- Reservoir of infection: In Bangladesh, India, Nepal only human.
C. Host factors:
- Age: All age group. But young adult are most common
- Sex: Males are more due to occupational exposure
- Population movement: Migration of population spread the kala-azar
- Socio-economic factors: It usually strikes the poorest of the poor
- Occupation: It strongly associated with occupational exposure
D. Environmental factors:
- Altitude: Mostly confined to plains and doesn’t occur in altitudes over 2000 feet
- Season: 3 months after the onset of rains
- Distribution areas: Generally confined to rural
- Vectors: Phlebotomus Argentipes
- Mode of transmission: Mostly person to person by bite of the female phlebotomize sandy
- Incubation period: Generally 2-4 months, the range being 10 days to over one year.
Mode of Infection of Kala-Azar:
➤ Vector borne transmission – Biting by infected sandfly.
➤ Direct transmission – Contamination of bite wound & Blood transfusion
➤ Congenital transmission – Transplacental transmission. It occurs rarely.
Pathogenesis:
Promastigote is carried by sandfly.
↓
Bite human.
↓
Promastigote enters into the body.
↓
Taken up by RE system.
↓
Promastigote is converted into amastigote.
↓
Multiply by binary fission within the cytoplasm of RE system
↓
Reduced bone marrow activity coupled with cellular destruction in the spleen.
↓
Striking enlargement of spleen.
↓
Anaemia, leucopenia and thrombocytopenia
↓
Generalized weakness, secondary infection and tendency to bleed.
Laboratory Diagnosis of Kala-Azar:
Principle: Leishmaniasis can be diagnosed by demonstration of the parasite (LD bodies) from the cutaneous, mucosal lesions and incase of visceral leishmaniasis from Bone marrow, Spleen or Lymph node aspirate. It can also be diagnosed by detection of antigen or antibody by immunological tests and isolation of the organism by culture if facilities are available. Nucleic acid techniques are also helpful.
Specimen collection: Aspiration of bone marrow, spleen, lymph nodes, buffy coat of blood
Microscopic examinations:
➤ Leishman (or Giemsa) stained smear
➤ Findings: amastigote form (LD bodies) in bone marrow, splenic aspirate and within blood monocyte.
Isolation and identification from culture:
➤ NNN media (Novy, Mac Neal, Nicole).
➤ Incubation- at 22° C.
➤ Incubation time-1 to 2 weeks.
➤ Findings- promastigote form of parasites are found,
Serological tests:
> Specific:
- For detection of antibody
✔ ICT (Immuno Chromatographic Test)
✔ DAT (Direct Agglutination Test)
✔ IFAT (Indirect Fluorescent Antibody Test)
✔ CFT (Complement Fixation Test)
- For detection of antigen-
✔ ELISA (Enzyme Linked Immuno Sorbent Assay)
✔ RIA (Radio Immuno Assay)
➤ Non-specific:
✔ Aldehyde test for detection of high globulin
✔ Antimony test
✔ Blood count-Decrease WBC, RBC, Platelet.
➤ NA based techniques: PCR (Polymerase chain reaction).
Clinical Features
Symptoms:
- Gradual onset of fever
- Low grade fever
- High intermittent fever
- Double rise of temperature in 24 hours
- Patient ambulant with good appetite and clean moist tongue
- Bleeding per nose
- Diarrhea
- Weakness (due to anemia)
- Cough (due to pneumococcal pneumonia, TB)
- Jaundice due to liver damage
Signs:
- Anaemia (+ve)
- Jaundice may be (+ve)
- Fever
- Skin pigmentation especially on face, dry, roughing
- Wasting
- Tongue is moist and clear
- Hepatosplenomegaly
Treatment:
A. Supportive Rx:
- Intercurrent infection should be controlled
- If severe anemia or bleeding is present, arrangement of blood transfusion
- Assessment of prognosis by measuring spleen size, Hb%, albumin
B. Specific Rx:
- Sodium stibogluconate 20 mg/kg/day, IV or IM for 20-30 days
If relapse: Sodium stibogluconate 20 mg/kg/day, IV or IM for 2 month - It patient fails to respond to antimonial drug, 2nd line of drug should be administered Pentamidine isothionate 3-4 mg/kg once or thrice weekly Amphotericin, Stibamidin, pantamidin
Complications of Kala-Azar
➤ Secondary bacterial infection, including pneumonia and tuberculosis.
➤ Septicemia.
➤ Disfigurement of nose, lips, and palate (eg, cancrum oris)
➤ Uncontrolled bleeding.
➤ Splenic rupture.
➤ Late stages: Edema, cachexia, and hyperpigmentation.